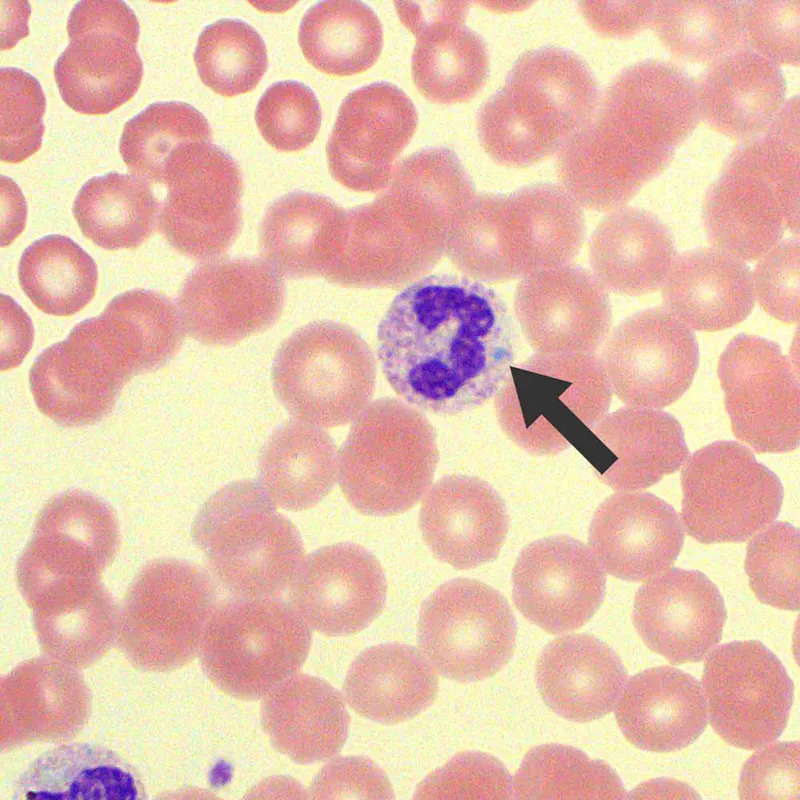
Toxic neutrophil with Döhle body

Fever - Body's Burning Defense
Error: Failed to generate content for this concept group.
Acute Phase Response - Protein Power‑Up
- Systemic inflammation response; liver boosts Acute Phase Protein (APP) synthesis.
- Major Inducers: IL-6, TNF-α, IL-1.
⭐ IL-6 is the principal cytokine stimulating hepatic synthesis of most acute phase proteins.
- Positive APPs (↑ levels):
- C-Reactive Protein (CRP): Opsonin, complement activation. Rapid.
- Serum Amyloid A (SAA): Recruits cells; AA amyloidosis risk.
- Fibrinogen: Clotting; ↑ ESR.
- Hepcidin: ↓ iron (absorption/release).
- Haptoglobin: Binds free Hb.
- Ceruloplasmin: Cu transport, antioxidant.
- Alpha-1 Antitrypsin: Protease inhibitor.
- 📌 Mnemonic (Key +ve APPs): Can He See Real Fine Art? (CRP, Hepcidin, SAA, Fibrinogen, Alpha-1 Antitrypsin). Also: Haptoglobin, Ceruloplasmin.
- Negative APPs (↓ levels):
- Albumin: ↓ synthesis, dilution.
- Transferrin: ↓ to sequester iron.

Leukocytosis - White Cell Warriors
- Increased WBC count, typically > 11,000/µL.
- Neutrophilia: Most common; bacterial infections, acute inflammation. Accelerated release from marrow (CSFs, IL-1, TNF), often with "left shift" (immature forms).
- Lymphocytosis: Viral infections (e.g., infectious mononucleosis).
- Eosinophilia: Allergic reactions, parasitic infections (IL-5 driven).
- Leukemoid Reaction: Extreme elevation, WBC > 50,000/µL.
- Caused by severe infections, inflammation, or paraneoplastic.
- Toxic changes in neutrophils: Toxic granulations, Döhle bodies, cytoplasmic vacuoles.
⭐ Leukocyte Alkaline Phosphatase (LAP) score is typically high in leukemoid reactions and low in Chronic Myeloid Leukemia (CML).
Systemic Syndromes - Inflammation's Wide Reach
-
SIRS (Systemic Inflammatory Response Syndrome): Widespread inflammatory state. Requires ≥2 criteria (📌 Mnemonic: "TEMPered Hounds Retch White BAIT"):
- Temperature: >38°C or <36°C
- Heart Rate: >90/min
- Respiratory Rate: >20/min or PaCO₂ <32mmHg
- WBC Count: >12,000/µL, <4,000/µL, or >10% immature band forms.
-
Sepsis Spectrum & Key Mediators:
-
Other Systemic Effects:
- Anemia of Chronic Disease: ↑Hepcidin blocks iron release/absorption, leading to ↓RBC production.
- Cachexia: Profound weight loss and muscle wasting; mediated by TNF-α, IL-1, IL-6.
- Acute Phase Response: Fever, leukocytosis, ↑plasma acute-phase proteins (e.g., CRP, fibrinogen).
⭐ TNF-α is a major mediator of cachexia (muscle wasting) and the profound hypotension seen in septic shock.
Lab Markers - Tracking Inflammation
- Erythrocyte Sedimentation Rate (ESR): Indirect measure; influenced by fibrinogen, immunoglobulins. Rises/falls slowly.
- C-Reactive Protein (CRP): Acute-phase reactant. Rises/falls rapidly (6-8 hrs peak). More sensitive for acute inflammation.
- Procalcitonin (PCT): Specific for bacterial infections; differentiates from viral/non-infectious causes.
- Leukocytosis: ↑ WBC count, especially neutrophils (neutrophilia); left shift.
⭐ CRP levels rise and fall more rapidly than ESR in response to inflammation, making it a better indicator of acute changes and treatment response.
High‑Yield Points - ⚡ Biggest Takeaways
- Fever: Mediated by PGE2 in hypothalamus, induced by IL-1, TNF.
- Acute Phase Proteins (APPs): CRP, SAA, fibrinogen synthesized in liver; ESR ↑.
- Leukocytosis: Neutrophilia (bacterial), lymphocytosis (viral), eosinophilia (parasitic/allergy).
- Sepsis: Life-threatening organ dysfunction from dysregulated host response to infection; TNF, IL-1, IL-6 are key.
- Anemia of Chronic Disease: ↑ Hepcidin blocks iron release.
- Cachexia: Weight loss and muscle wasting, often TNF-α mediated.
Unlock the full lesson and continue reading
Signup to continue reading this lesson and unlimited access questions, flashcards, AI notes, and more